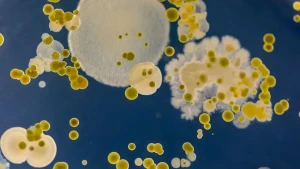

В една от лабораториите в София, където през последните седмици се отчита засилен поток от пациенти, най-често се правят бързи тестове за грип А и Б и COVID-19, включително комбинирани.
Медицинският директор на лабораторията д-р Благовеста Пенчева съобщи, че за последните два месеца броят на тестовете е нараснал осезаемо, като само изследванията за COVID са с над 200 повече спрямо предходния период. По думите ѝ тенденцията е ясна – приблизително всеки трети бърз тест за грип дава положителен резултат.
„Това показва сравнително висока циркулация на вируса“, обясни д-р Пенчева, като уточни, че смесени инфекции почти не се срещат. Аналитичната надеждност на тестовете е висока, като възможната грешка е между 3 и 5 процента – в рамките на приетите медицински стандарти.
Според директора на лабораторията най-подходящият момент за тестване е при първите симптоми на грип – внезапна висока температура, силна отпадналост и мускулни болки.
Доц. Ангел Кунчев определи развитието на грипния сезон като по-скоро благоприятно. По думите му заболеваемостта в страната се повишава, но с по-бавни темпове в сравнение с миналата година.
Средната стойност за България към момента е около 150 на 10 хиляди души, макар че в някои области тя значително надхвърля тези нива. Пловдив вече е над 250 на 10 хиляди, а Смолян и Ямбол са сред регионите, за които се очаква да достигнат епидемични стойности.
Области без епидемия
„Вероятно немалка част от областите изобщо няма да стигнат до обявяване на грипна епидемия“, коментира доц. Кунчев пред NOVA. Очакванията му са до краят на януари и началото на февруари да бъдат пикът на заболеваемостта, като евентуално застудяване може да ограничи интензитета на разпространение.
Данните от Националния център по заразни и паразитни болести показват, че в момента доминира грип А, по-конкретно щамът H3N2. От около 500 изследвани проби близо 140 са положителни именно за този вирус, докато други респираторни причинители се откриват значително по-рядко. В края на сезона е възможно да се появи и грип B, който понякога води до по-слаба втора вълна.
По отношение на лечението доц. Кунчев подчерта, че при първи симптоми е важно навременното приемане на антивирусни лекарства с доказан ефект.
„Няма вещество без горна граница -премине ли се тя, ефектът може да бъде обратен“, посочи главният държавен здравен инспектор във връзка с опасността от предозиране с хранителни добавки.